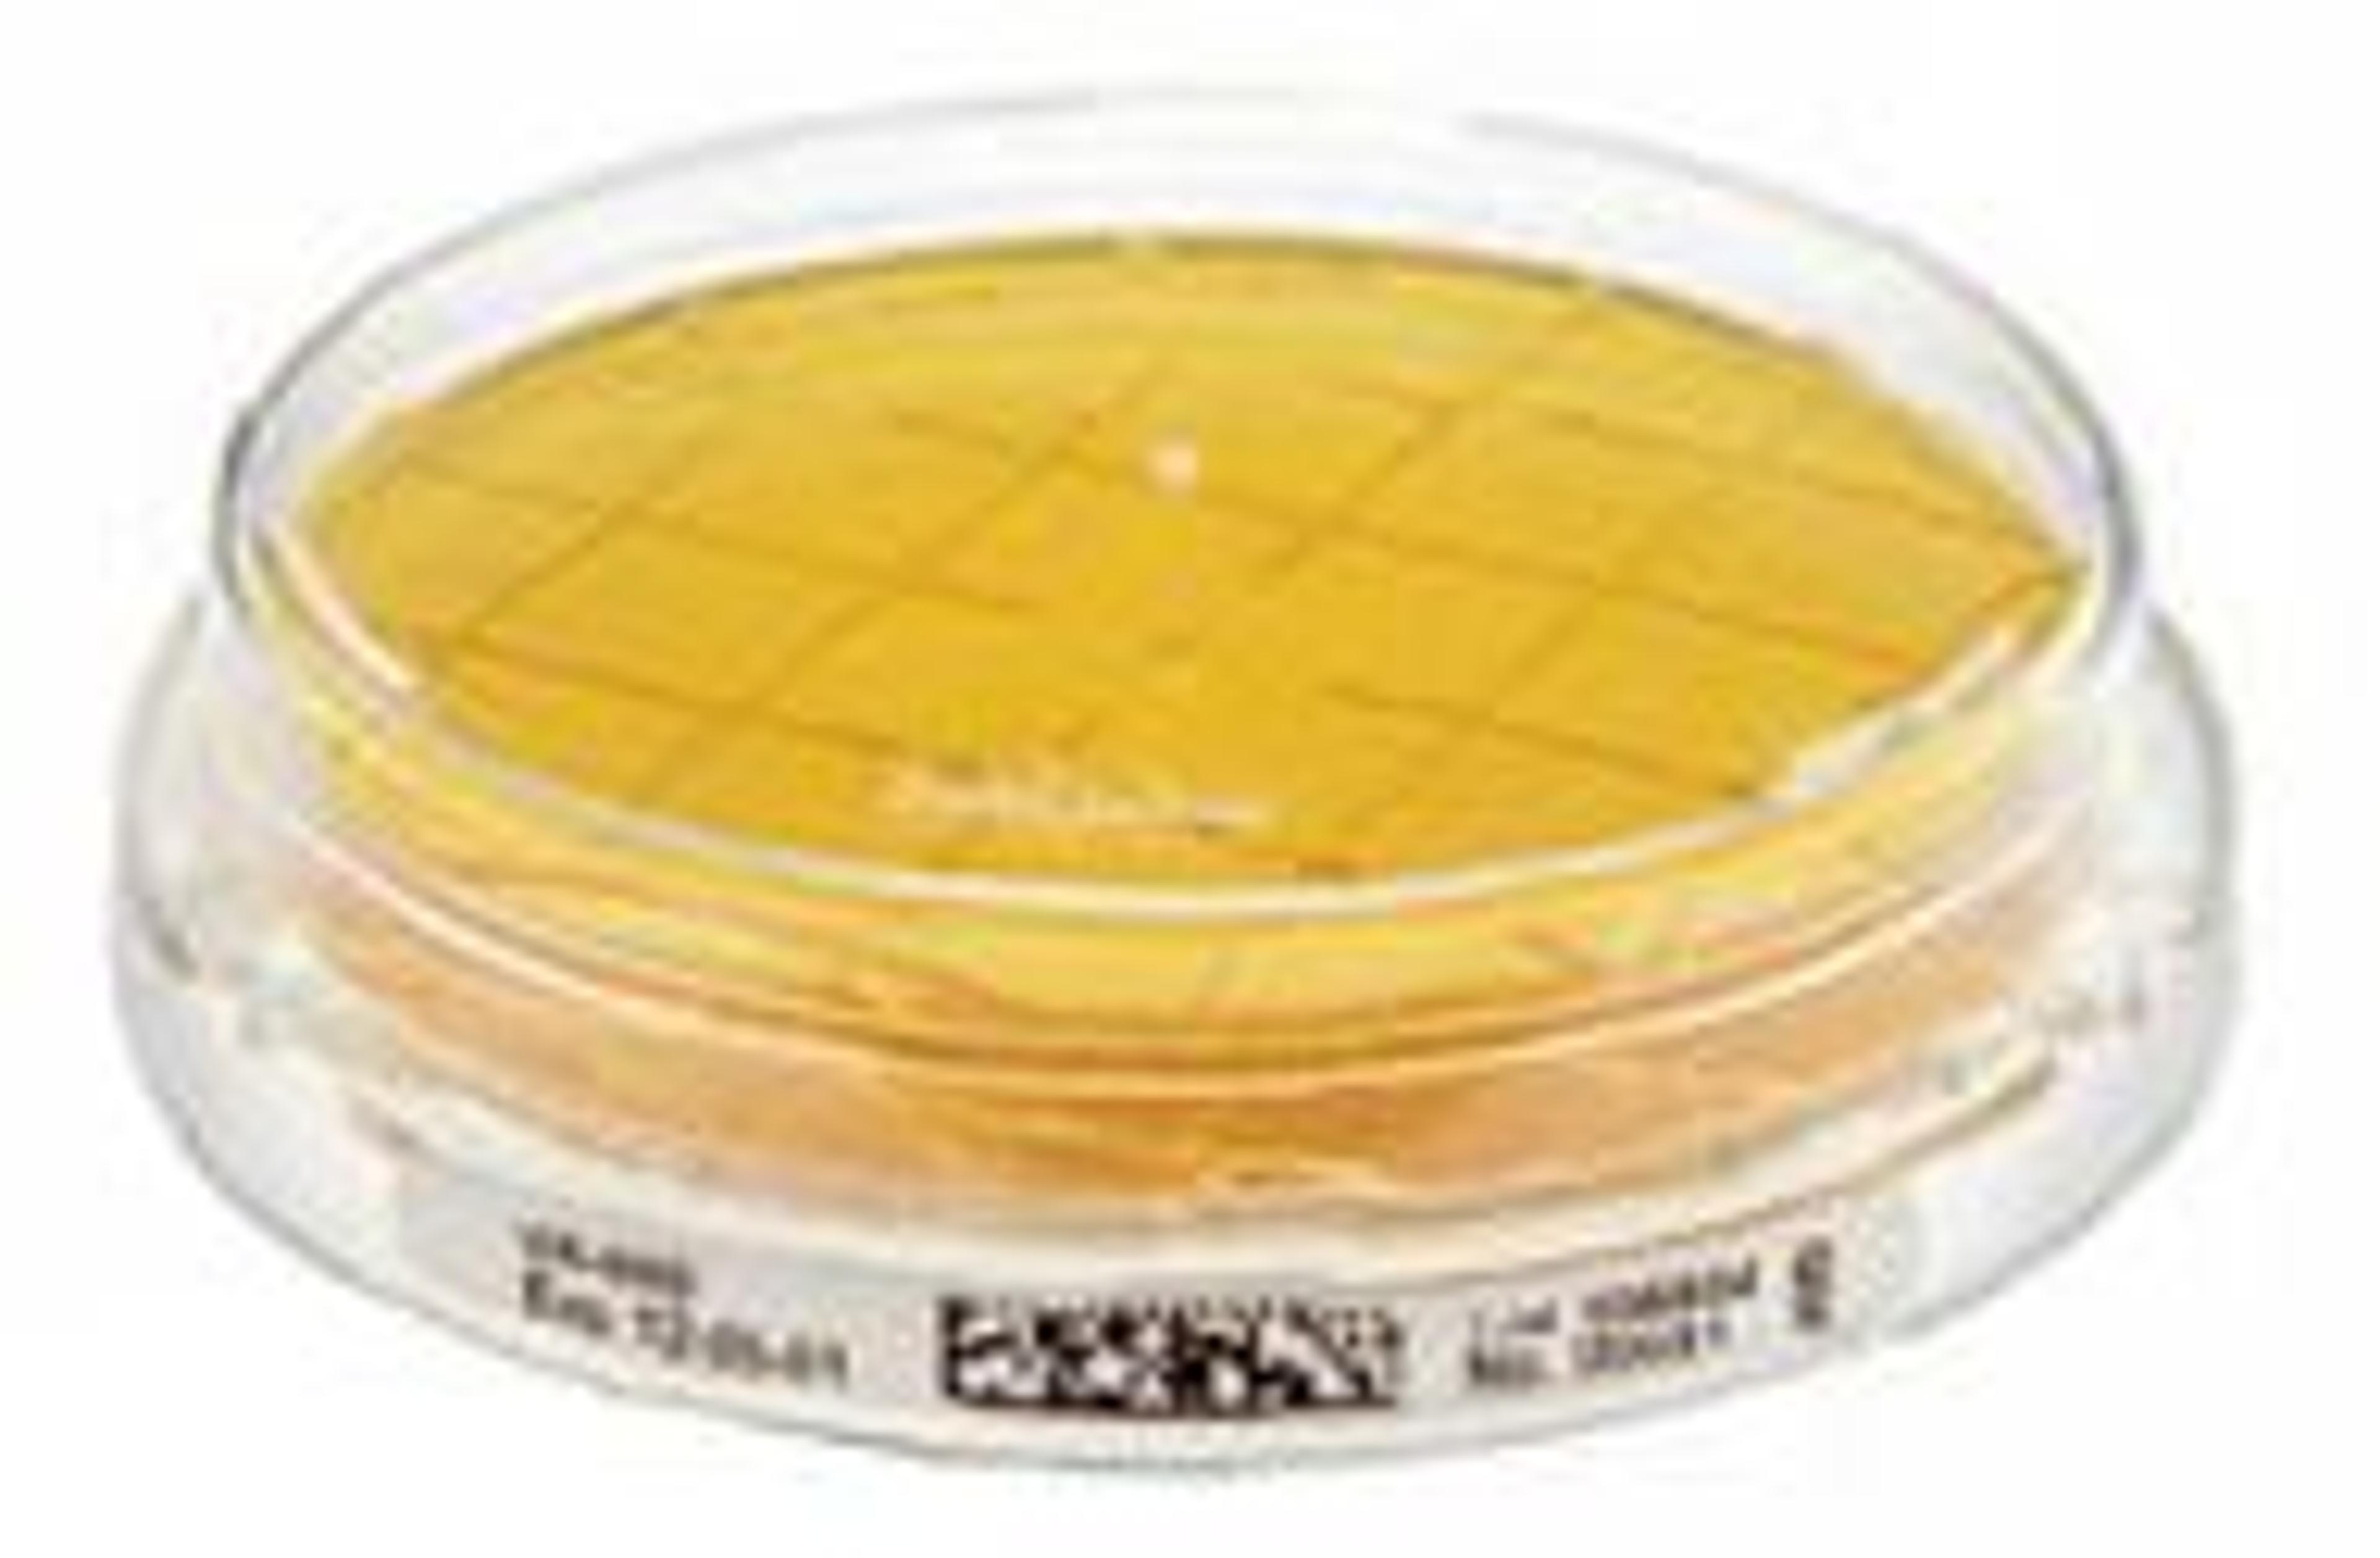

resDetect™ T7 RNA Polymerase ELISA Kit (Residue Testing)
ACROBiosystemsresDetect™ T7 RNA Polymerase ELISA Kit uses the ELISA sandwich method to detect and quantify T7 RNA Polymerase residues in mRNA drugs. It includes T7 RNA Polymerase (ACROBiosystems, cat# T7E-E5143) for accuracy and ensures reliable monitoring during mRNA production. The kit also serves as a universal tool for T7 RNA Polymerase quantification.